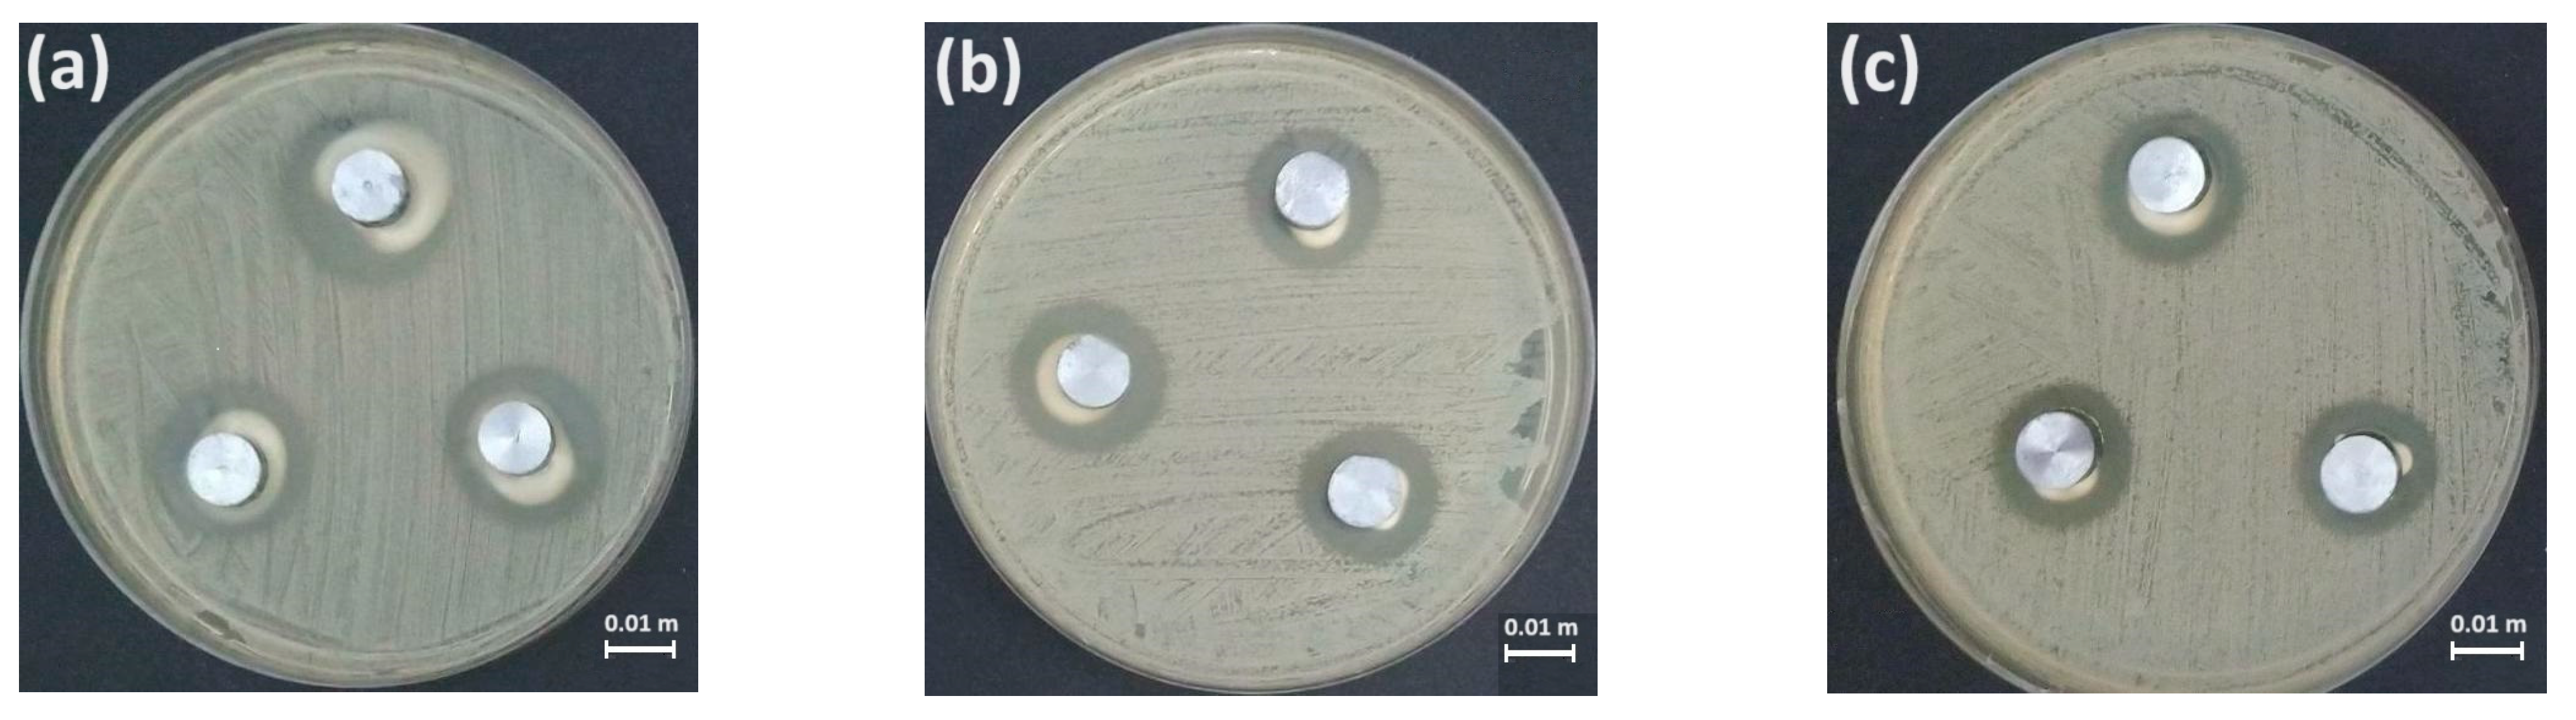
Metals 14 00740 g009

Abstract
Zn-Ag-Cu alloys have recently attracted attention as alloy candidates for biomedical applications, but, to date, they have not achieved the required mechanical properties. To improve the mechanical properties of Zn-Ag-Cu-base alloys, in this work, the effects of the presence of increasing amounts of Ag and Cu as alloying elements on the properties of four 0.05% Mg-micro-alloyed Zn-Ag-Cu base alloys are explored. The alloys were manufactured in an electric furnace with a protective atmosphere using increasing amounts of Ag and Cu as alloying agents, and were cast in a metallic mold. The samples obtained were thermomechanically processed by hot extrusion. Three of the four alloys under study presented increasing amounts of the second phase (Ag, Cu)Zn4, high mechanical properties, a microstructure and mechanical behavior characteristic of heteromaterials with a heterogeneous lamella-structure, and met the requirements of the mechanical properties, corrosion rate, antibacterial properties against S. aureus, and the cytotoxicity required for biomedical applications. It seems possible to tune the properties of the ZnAgCu-0.05% Mg alloys by changing the Ag and Cu contents.
1. Introduction
In recent years, numerous efforts and advances have been made to develop new zinc-based biomedical alloys, looking for suitable properties for use in stents and orthopedic internal fixation devices. The main problem with these alloys is the low mechanical properties associated with zinc. This problem has been partially addressed by using selected alloying elements and processing routes to provide a microstructure that gives the alloy the required characteristics, including mechanical, corrosion, cytotoxicity, and antibacterial.
The second phase plays a relevant role in improving the properties of zinc-based biomedical alloys. Shi et al. [1] found, considering 23 possible non-toxic alloying elements, that Ag and Cu are among the five most promising elements for improving the mechanical properties of zinc-based biodegradable alloys. This selection occurs given the high solubility in zinc of Ag and Cu, which produces solid solution hardening and precipitation hardening. This choice was also influenced by its high efficiency in forming second intermetallic phases (AgZn3 and CuZn4), defined by the increase in the volume fraction of the second phase and an increase in the atomic percentage of each element. These two alloying elements show potential antibacterial and biocompatibility abilities [2,3,4]. Due to the unique properties conferred by Ag additions, they have also been studied in Mg-based biomedical alloys. Nie et al. [5] studied the effect of Ag additions in the Mg-3Nd-0.2Zn-0.4Zr system and found that an increase in Ag increases the elongation and corrosion rate and can improve the mechanical strength.
In Zn-Ag and Zn-Cu binary alloys, it has been found [6,7] that as the alloying element content increases, the mechanical properties increase, both in terms of yield stress, YS, and ultimate tensile strength, UTS, as well as in the percentage of elongation, %El. This behavior is associated with the presence, in each case, of the second phases AgZn3 and CuZn4, which present the same hexagonal close-packed (HCP) crystalline structure as the zinc matrix, as well as various orientation relationships (OR) between the intermetallics and the zinc matrix [8,9]. These structural similarities and OR allow, on the one hand, for the compatibility of the phases during their plastic deformation. Additionally, the second phase particles act as nucleation sites for zinc grains during their dynamic recrystallization.
Since the mechanical properties in these binary alloy systems are below those required for biomedical applications, for example, stents require a yield stress, YS, greater than 200 MPa, an ultimate tensile strength, UTS, greater than 300 MPa, and a percentage of elongation, %El) greater than 15–18% [10], the addition of micro alloys has been explored to improve them. In the case of Zn-Cu alloys, some improvements were reached by adding Fe [10], Mg [11] and Ti [12]. In the case of Zn-Ag alloys, good results were obtained by adding Mg [13,14], and notably with additions of Mn [15].
Given the clear advantages of using Ag and Cu as alloying elements for zinc, Zn-Cu-Ag ternary alloys have been developed with promising results in recent years. Di et al. [4] studied the microstructure, mechanical properties, corrosion behavior, and antibacterial properties of hot extruded Zn-1 wt% Cu-0.5 wt% Ag and Zn-1 wt% Cu-1 wt% Ag alloys. They found that the Zn-1 wt% Cu-1 wt% Ag alloy had a maximum tensile strength, UTS, = of 292 MPa, a yield stress of YS = 269 MPa, and an elongation of % El = 36%.
Jin et al. [16,17] studied the effects of Ag and Zr contents and hot rolling on the microstructure and mechanical properties of Zn-1.5 wt% Cu-Ag-Zr, finding that, after hot rolling, the mechanical properties improved significantly. The best mechanical properties were obtained for the Zn-1.5 wt% Cu-1 wt% Ag-0.1 wt% Zr alloy, with the following properties being YS = 218 MPa, UTS = 245 MPa, % El = 64%, respectively.
Niu et al. [18] studied the effects of Cu and Mn additions on the microstructure, the mechanical and corrosion properties, and the antibacterial activity of the Zn-4 wt% Ag alloy. They found that adding one wt% Cu improved the mechanical properties and the degradation and antibacterial rates of Zn 4 wt% Ag alloys.
Guillory et al. [19] studied the biocompatibility of three zinc—based silver (Ag)-containing alloys: Zn-4 wt% Ag, Zn-4 wt% Ag-0.6 wt% Mn, Zn-4 Ag-0.8 wt% Cu-0.6 wt% Mn-0.15 wt% Zr. The homogenized alloys were later extruded to obtain cylindrical rods. The extruded rods were cold-drawn and heat-treated. The results suggest that the five element alloy system (Zn-4 wt% Ag-0.8 wt% Cu-0.6 wt% Mn-0.15 wt% Zr) performed significantly better, obtaining the following properties after heat treatment with a cold drawn wire: YS = 224 MPa, UTS = 289 MPa, % El = 33%.
Yilmazer et al. [20] studied Zn-1 wt% Cu-X Ag alloys with Ag contents between 0 and 4 wt% Ag, obtained by casting under a vacuum atmosphere, homogenization, and quenching. The maximum hardness value of the Zn-1 wt% Cu-4 wt% Ag alloy was more than two times higher than that of pure zinc due to the solid solution strengthening and precipitation hardening of (Ag, Cu)Zn4 phases, and the inhibition ratio of the Zn-1 wt% Cu-1 wt% Ag was higher than the inhibition rate of the other alloys on E. coli and S. aureus.
Heiss et al. [21] developed ternary and quaternary precipitation-hardening alloys based on the Zn-Ag-Cu alloy system using thermodynamic calculations and experimentation, which included obtaining the as-cast alloys and their thermomechanical treatment of homogenization and hot and cold rolling. Using the thermodynamic simulations, they selected the ternary alloy Zn-2.5 wt% Ag-1.5 wt% Cu and two quaternary variants of this alloy, with Li and Mn micro alloys. Their results indicate that micro alloys with Li and Mn improved the properties of the ternary alloy.
Chen et al. [22] created a Zn-1.5 wt%Cu-1.5 wt% Ag alloy. They found that (Ag, Cu) Zn4 is the only secondary phase, and this second phase successfully produced a bimodal grain size distribution and remarkably dispersive (Ag, Cu)Zn4 particles. After being hot extruded, this alloy showed the following properties: YS = 162 MPa, UTS = 220 MPa, and % El = 44%. After being aged at room temperature for eight months, its mechanical properties increased by about 10%, which implies good anti-aging ability.
The aging phenomenon of the rapid deterioration of elongation during storage at room temperature is another aspect that restricts the application of Zn-based alloys in biomedical applications. The thermomechanical processing of alloys results in the formation of a supersaturated solid solution that is thermodynamically unstable and that, during storage at room temperature, presents the precipitation of secondary phases that cause undesirable mechanical instability [23]. In the case of the alloy developed by Chen et al. [22], aging causes the precipitation of (Ag, Cu)Zn4, a relatively ductile secondary phase. Therefore, the alloy shows an increase in its mechanical strength and elongation after a natural aging period of 8 months. In contrast, some Zn-Mg alloys exhibit natural aging that causes the precipitation of Mg2Zn11, an extremely brittle phase that causes a considerable decrease in elongation after short storage times. Jin et al. [24] sought to improve the mechanical properties of Zn by micro alloying with Mg (<0.1 wt% Mg) and obtained, by hot extrusion, a Zn-0.08Mg alloy with YS = 250 MPa, UTS = 266, and % El = 29.8%. However, due to aging, after nine days of storage at room temperature, the elongation dropped to 12.7%. Ardakani et al. [25] and Chen et al. [23] found that it is possible to reduce the aging and maintain the improvements in the mechanical properties associated with the micro-alloy of Zn with Mg (<0.08 wt% Mg) through additions of Cu and Ag. Their results suggest the existence of an interaction of Cu and Ag with Mg, which remains in a solid solution for a longer time and maintains the increase in the mechanical properties associated with adding Mg without much loss of plasticity.
It should be noted that in the Zn-Cu-Ag ternary alloys reported so far, relatively low Cu and Ag contents have been maintained, which has resulted in the absence or reduced contents of the second phase (Ag, Cu)Zn4 despite the potential advantages that the more significant quantities of the second phase would imply. In this regard, two or more phases in proportional quantities comparable to those of the matrix can impart unique and improved mechanical properties to one multiphase alloy [26]. These properties are generated through interactions between the constitutive phases subjected to stress and plastically deformed, manifested through the so-called hetero-deformation mechanisms [27,28]. Considering that the content of the second phase increases as the alloy content increases, it is possible to improve the properties of these alloys by increasing the Ag and Cu contents.
For this purpose, we selected four alloys based on the Zn-Ag-Cu ternary diagram [29], three of them with ascending second phase contents and another located in the monophasic stability area, as a control alloy.
Considering that to date, the Zn-Ag-Cu alloys reported in the open literature have not reached the mechanical properties required for biomedical applications, and taking into account the results of the improvement in properties and the reduction in microstructural instability problems in the Zn-based alloys linked to microalloying with Mg in the presence of Cu and Ag reported by Ardakani et al. [25] and Cheng et al. [23], we used, in all cases, experimental alloys micro-alloyed with 0.05% Mg.
This Mg content seeks to promote the presence of Mg precipitates to improve the mechanical properties of the Zn-Ag-Cu alloys, and to avoid an excessive drop in ductility [24]. This level of Mg microalloying has shown good anti-aging behavior, low cytotoxicity, and good bone regenerative potential [30].
Accordingly, this work explores the effect of Ag and Cu content on the microstructure and the mechanical, corrosion, antibacterial, and cytotoxicity properties of Zn-Ag-Cu-0.05 wt% Mg hot extruded quaternary alloys to determine their suitability for biomedical applications.
2. Materials and Methods
2.1. Material Preparation
Four Zn-Ag-Cu-0.05 wt% Mg quaternary alloys with different Ag and Cu contents were manufactured. The compositions were selected using the Zn-Ag-Cu ternary phase diagram [29] as a reference, to increase the amount of the second phase gradually in the as-cast alloys. Their chemical composition was determined using ICP-OES. Pure zinc and Zn-10 wt% Cu, Zn-20 wt% Ag, and Zn-3 wt% Mg master alloys were used to obtain the quaternary alloys. First, the zinc is added to a graphite crucible placed inside an electric furnace at 650 °C under an Ar protective atmosphere, according to the required mass percentage, until it melts. Then, the master alloys are added in the following order: Zn-10 wt% Ag, Zn-20 wt% Cu, and finally the Zn-3 wt% Mg alloy, until their dissolution is reached. Once this last addition dissolves, argon is introduced into the bath for degassing through a lance. Finally, the liquid alloy is poured into a metal mold with a cylindrical geometry and is allowed to solidify and cool to room temperature. A homogenization treatment was applied to each specimen at 340 °C for 48 h, followed by cooling in water at room temperature. Finally, the homogenized bars were preheated to 340 °C and then hot extruded, with an extrusion ratio of 16:1. The extruded product was sectioned into bars for subsequent machining.
2.2. Microstructure Analysis
The microstructure was analyzed in the as-cast and extruded samples. The samples were cut, their surface was prepared for metallographic observation by grinding and polishing, and a chemical attack was used to reveal the microstructure. In the case of the extruded pieces, the cross-section of the rod was observed parallel to the extrusion direction. The chemical attack was carried out using a solution [22] of the following composition: 50 g CrO3, 15 g NaSO4, and 1000 mL distilled water. The samples were analyzed with an Olympus optical microscope at different magnifications. The alloys’ scanning electron microscopy (SEM) analysis was conducted in a JEOL model JSM-6060LV microscope (JEOL Ltd., Tokyo, Japan). The IMAGEJ software (version 1.53t) was used to measure the percentage of secondary phase in the as-cast and extruded alloys. This percentage was quantified by processing at least ten micrographs at low magnification (50×), obtained for each alloy in its cast and extruded states. X-ray diffraction tests were performed using a Rigaku diffractometer, DMAX 2200 (RIGAKU, Tokyo, Japan), with a Cu anode, K α = 1.54 A.
2.3. Mechanical Properties Testing
The tensile tests were carried out according to the ASTME8-04 [31] standard at room temperature, using an INSTRON 5500R (INSTRON, Norwood, MA, USA) at a crosshead speed of 0.001 m/min. The dimensions of the tensile test specimen, with a gauge length of 0.025 m, are shown in Figure 1.
Figure 1.
Dimensions of the tensile test specimen.
2.4. Corrosion Rate
The immersion test was used to measure the corrosion rate of the samples under study; the samples were immersed in Hank’s solution as SBF (Simulated Body Fluid) at 37 °C. The tests were carried out in triplicate for the alloys under study; the corrosion rates were determined by gravimetry. The samples were removed from the immersion solution after 33 days and cleaned using ultrasound in a chromate solution (200 g/L CrO3 + 10 g/L AgNO3) to remove surface corrosion products, followed by drying with hot air. Finally, before the final weighing, the samples were washed in an ultrasonic bath with 70% ethanol and dried. An analytical balance was used to measure the weight of the sample before and after immersion.
The corrosion rate CR was determined using Equation (1):
where CR is the corrosion rate (milliliters per year);
Δp is the weight loss (grams), which is obtained by subtracting the final weight of the sample (grams) from the initial weight;
ρAp is the apparent density of the sample, obtained by dividing the initial weight of the sample by its volume (grams per cubic milliter);
and t is the exposure time (years).
2.5. Antibacterial Tests
The antibacterial activity was evaluated according to ISO 20645-2004 [32]. The model bacteria used to assess the antibacterial activity was S. aureus. The extruded products of experimental alloys were machined into discs 0.004 m high and 0.01 m in diameter. Eight kilograys of radiation was applied to sterilize the material for its biological evaluation. The strain of S. aureus ATCC 25923 was used, and the number of bacteria used in the assay was 31.5 × 106 per milliliter. For each alloy, a box of Mueller Hinton agar from this concentration was inoculated with swabs, and then samples of the alloy (three pieces) were placed in it. The box was incubated at 37 °C for 24 h; after the incubation period, the diameter of the inhibition halos was determined. According to the standard ISO 20645-2004 [32], the size of the inhibition zone diameter (IZD) around the alloy was observed and measured, and the calculation, using Equation (2), evaluated the anti-bacterial performance of the material:
where D refers to the total inhibition zone diameter in mm, and d refers to the diameter of the sample in millimeters. When IZD > 0.001 m, the material has good antibacterial properties [4]. The D and d values were determined by the image analysis method via Image J software. The antibacterial assays were performed at least in triplicates, and the IZD values were averaged.
2.6. Cytotoxicity Tests
The cytotoxicity of the alloy with the highest content of alloying elements, alloy A4, was evaluated, assuming that the results obtained with this alloy can represent the rest of the experimental alloys. It was considered that if the alloy with the highest alloy content presented acceptable cytotoxicity, the rest of the experimental alloys with the same alloying elements but in lower quantities could also present a satisfactory performance. The extruded product was machined into discs 0.004 m high and 0.01m in diameter. Eight kilograys of radiation sterilized the material for biological evaluation.
Following ISO 10993-5:2009 [33], three vials of NCTC clone 929 (L929) cells, obtained from the American Type 2 Culture Collection (ATCC), were thawed and seeded in Eagle’s minimal essential medium (EMEM) with 10% FBS at 37 °C and 5% CO2 until they reached sufficient confluency to be seeded at a rate of 20,000 cells per well in 96-well plates. Twenty-four hours later, the culture medium was changed to a medium with different concentrations (%) of the material elution, from 10 to 100% for the bullion. It was left to act for 24 h and observed under a microscope.
Cytotoxicity was evaluated only for the extruded A4 alloy; antibacterial tests were performed only for the extruded A2, A3, and A4 alloys by triplicate. The four extruded alloys were tested for mechanical properties by triplicate, and the corrosion rate by immersion test also by triplicate. In the case of MO and SEM, the four alloys were examined in the as-cast, homogenized, and extruded conditions using samples in triplicate. DRX characterization was performed on one sample for each extruded alloy.
3. Results
Table 1 shows the chemical composition of the experimental alloys determined by ICP-OES. The selected compositions were designed to increase, from the top to the bottom of the table, the Ag and Cu contents, taking into account the available information from the Zn-Ag-Cu ternary phase diagram in the zinc-rich region reported in the literature [29], maintaining the Mg content around 0.05 wt%. Increasing the amount of these alloying elements aims to gradually increase the second phase’s content in the presence of minor amounts of Mg precipitates.
Table 1.
Chemical compositions of the experimental alloys.
3.1. Microstructural Characterization
Figure 2 and Figure 3 show the microstructures obtained by optical microscopy of the alloys under study in their as-cast and extruded states, according to the characterization carried out by SEM and X-ray diffraction, XRD. As shown later, from the experimental chemical compositions shown in Table 1, and the Zn-Ag-Cu phase diagram [29], it is reasonable to assume that (Ag, Cu) Zn4 is the secondary phase, observed as a bright phase in the A2, A3, and A4 alloys, and that the dark phase is the zinc matrix.
Figure 2.
Images of the microstructures obtained by optical microscopy.—(a) alloy A1 in its cast state, (b) alloy A1 hot extruded; (c) alloy A2 in its cast state, (d) alloy A2 hot extruded.
Figure 3.
Images of the microstructures obtained by optical microscopy. (a) alloy A3 in its cast state, (b) A3 hot extruded; (c) alloy A4 in its cast state, (d) A4 hot extruded.
Figure 2a shows that alloy A1 consists of zinc solid solution dendrites in the as-cast state. In the cases of alloys A2, A3, and A4, Figure 2c and Figure 3a,c, respectively, show that these alloys consist of a zinc matrix, which is the dark phase that appears as a dark gray background in the micrograph, and from the second phase it appears as bright dendrites.
After thermomechanical processing, the micrographs presented in Figure 2b,d for samples A1 and A2, and 3b and 3d for samples A3 and A4 were obtained. In these figures, the zinc matrix appears as small recrystallized grains, which appear in the micrograph as a dark gray background, and the second phase, (Ag, Cu)Zn4 appears as bright deformed areas, forming bands in the direction of extrusion. The deformation shown by the second phase is evidence of the compatibility in the deformation of the zinc matrix and the second phase, since both have the same HCP crystalline structure [7,8]. The micrographs shown in Figure 2 and Figure 3 indicate that as the percentage of alloying elements increases, the secondary phase considerably increases in both the as-cast and extruded states. Alloy A4 shows the most significant amount of the second phase (see Figure 3c,d. When comparing these Figures with Figure 3a,b, corresponding to alloy A3, an apparent decrease in the appreciable amount of the second phase is noted.
The same happens for alloy A2, which shows an even smaller amount of second phase (Figure 2c,d while there is no second phase in the sample with the lowest Ag and Cu contents, alloy A1. In the as-cast state, alloy A1 shows a dendritic structure of zinc solid solution, (Figure 2a), and it is worth highlighting the large size of the grains that can be seen in the extruded sample (Figure 2b), apparently as a result of the dynamic recrystallization of zinc matrix in the absence of second phase.
Table 2 shows the percentages of secondary phases present in the alloys in their as-cast and extruded states. As seen in this table, alloys A2, A3, and A4 showed the presence of a secondary phase, while alloy A1 did not have a second phase, as seen in Figure 2 and Figure 3. As the Ag and Cu contents increase, as seen from top to bottom in Table 1 and Table 2, the second phase content increases. The results in Table 2 also show that, due to the processing, there is a slight decrease in the second phase content in the extruded alloys, concerning the amount of the second phase appearing in the as-cast state. This decrease in the second phase is associated with the homogenization treatment, in which the diffusive processes activate the transformation of the metastable part of the second phase that did not transform during the peritectic reaction.
Table 2.
Percentage of the second phase in the alloys under study in their as-cast and extruded state.
Regarding the increase in second phase amount as the alloy content increased, the differences were more significant, with an increase in the copper content by about 1 wt% under similar Ag contents (5 wt%) (Alloys A3 and A4) compared to the increase in the second phase caused by the rise of approximately 1 wt% of Ag, maintaining roughly the same copper content (2 wt%) (Alloys A2 and A3). The above is associated with the fact that the maximum solubility of Cu in Zinc at the binary peritectic temperature is around 2 wt%, as the Zn-Cu binary phase diagram indicates. In comparison, that of Ag in Zn at the binary peritectic temperature is around 8 wt%, indicating the ability of Ag to remain in a solid solution without forming a second phase, more so than Cu. Another explanation for this behavior is that, for the levels of alloying present in alloys A3 and A4, the solid solution is saturated and is more sensitive to forming a second intermetallic phase as the Cu content increases.
Alloys A2, A3, and A4 show the same microconstituents. The electron microscopy results of alloy A4 below represent the microstructural features also observed in alloys A2 and A3. Figure 4 shows the micrographs at low magnifications obtained by the SEM of alloy A4 following its processing route: as-cast, (Figure 4a), after homogenization treatment, (Figure 4b), and extruded (Figure 4c). In the as-cast state, as seen by optical microscopy, the second phase appears as light gray dendrites embedded in a dark matrix of zinc solid solution. During the homogenization treatment, a small percentage of the Cu and Ag in the second phase dissolves in the solid solution to saturate it. The contours that separate the second phase smoothed, as seen in Figure 4b. Because of hot extrusion, the second phase deforms into bands in the direction of extrusion and partial fragments, as seen in Figure 4c. In contrast, the zinc solid solution matrix dynamically recrystallizes in the form of small grains that tend to be equiaxed and with grain boundaries decorated by small second-phase precipitates, which precipitated during the thermomechanical processing and limited the growth of zinc grains during their recrystallization. The recrystallized zinc grains decorated at their boundaries by second-phase particles are appreciated more clearly in Figure 4d, taken at higher magnifications.
Figure 4.
Main microconstituents present in alloy A3 (a) As-cast state, (b) after homogenization treatment; (c) hot extruded and (d) hot extruded at higher magnifications.
Figure 5 shows the SEM image and EDS analysis of the eutectic of Mg and Zn in the as-cast A4 alloy, and Mg-rich precipitates in the homogenized A4 alloy. Figure 5a indicates that eutectic forms in the interdendritic zones of the dark gray phase, which is the solid zinc solution. The eutectic morphology shows the typical laminar nature, and the cross shows the position of the EDS determination. In Figure 5b, the EDS results show, as expected, the presence of Mg in the eutectic.
Figure 5.
(a) Image, the cross indicates the position of the EDS analysis, (b) EDS of the Zn-Mg eutectic constituent in alloy A3 in as-cast state; (c) The line shows the trajectory of the EDS Linescan of black precipitates at the Second phase/matrix interphase showing the presence of Mg.
During solidification, eutectic colonies form not only in the interdendritic regions of the solid zinc solution. An SEM microstructural analysis revealed the presence of areas with Mg at the boundaries between the second phase and the solid zinc solution. Figure 5c depicts the images and line scan results showing the presence of Mg in the black precipitates formed at the interface between the second phase and the matrix of A4 alloy after homogenization. The presence of these precipitates may be explained because of the diffusive and interfacial phenomena activated by the homogenization treatment, transforming as-cast Zn-Mg eutectic, integrating the zinc platelets to the zinc matrix, and forming the black Mg-rich precipitates observed in the experimental alloys. These precipitates may be identified as the intermetallic Mg2Zn11, but further research is needed to confirm this hypothesis.
Figure 6 shows the atomic mapping of the extruded A4 alloy, indicating that most of the Ag and Cu are located in the second phase.
Figure 6.
(a) Alloy A4 in its extruded state and atomic mapping of (b) Cu and (c) Ag.
Figure 7 shows the X-ray diffraction results. These results detected the presence of two microconstituents in the experimental alloys: the solid solution of zinc and the second phase constituted by the intermetallic compound (Ag, Cu)Zn4. Figure 7 shows the X-ray diffraction results for the experimental alloys. It can be seen that, in addition to the α-Zn peaks, which are the only ones that appear in alloy A1, the other diffraction peaks shown by alloys A2, A3, and A4 correspond to (Ag, Cu)Zn4. No peaks derived from Mg were detected due to its reduced content, which was below the sensitivity limit of XRD.
Figure 7.
XRD pattern of the alloys under study.
Although it would be necessary to corroborate irrefutably using more sophisticated microstructural characterization techniques, the identity of the microconstituents present in the experimental alloys, the analysis of the microstructural characterization results by optical microscopy, scanning electron microscopy, and X-ray diffraction, and the reported results of zinc based alloys with similar microalloying content of Mg [23,24,25,30], suggest that alloys A2, A3 and A4 show three microconstituents. These are the second phase , the α- zinc matrix phase and intermetallic . Alloy A1 presents two microconstituents: the α-Zn matrix phase and intermetallic .
3.2. Corrosion Rate
Table 3 shows the corrosion rate results obtained through the immersion test. It shows that, as the percentage of the secondary phase increases, the corrosion rate increases, with the highest corrosion rate for alloy A4 at 0.12 ± 0.03 mm/year. An increase in the corrosion rate as a result of the increase in the second phase has been associated [34,35] with the number of galvanic microcells, where the second phase is the cathode and the zinc matrix is the anode, which increases as the alloy content and the percentage of the second phase increase. This behavior is observed in the binary alloys Zn-Ag and Zn-Cu. Xiao et al., 2021 [34] and Palai et al., 2022 [35] found that for Zn-Ag and Zn-Cu alloys, respectively, the increase in the corrosion rate, observed in the immersion tests as the alloy content increases, is explained as a result of micro galvanic corrosion between the second phase (AgZn3 and CuZn4, respectively) that serves as the cathode, and the zinc matrix as the anode. The difference between the corrosion rates of the alloys depending on the alloy content is explained in terms of the number of micro galvanic cells and the percentage of the area occupied by zinc, both dependent on the amount of second phase present [35].
Table 3.
Corrosion rate results obtained through the immersion test.
In the case of Zn-Ag-Cu base alloys, Chen et al. [22] reports for the Zn-1.5 wt% Ag-1.5 wt% Cu alloy that during the immersion test there is a weak passivation process, indicating the formation of a poorly protective passive layer when the alloy is immersed in Hank’s solution. As the standard potential of the secondary phase is usually higher than that of the zinc matrix, when the film breaks, the zinc matrix, in contact with the secondary phase, dissolves by micro galvanic corrosion, and that this corrosion behavior has been observed in many Zn-based alloy systems.
Niu et al. [18] studied the corrosion of Zn-4 wt% Ag-1 wt% Cu, Zn-4 wt% Ag-1 wt% Mn, and Zn-4 wt% Ag in Hank’s solution and found that these alloys presented an initial dissolution process, followed by the formation of a protective passive film of corrosion products. This film caused a decrease in the corrosion rate of the three alloys as the test time passed. They also found that the alloy that presented the most corrosion products was Zn-4 wt% Ag-1 wt% Mn, which presented the highest corrosion rate and the highest percentage of the second phase, followed by the Zn-4 wt% Ag-1 wt% Cu alloy. Given the above, they concluded that the role of corrosion products may be twofold, causing on the one hand an accumulation of corrosion products that inhibited the process and on the other hand, with their disintegration, allowing the Zinc and the second phases to form micro galvanic cells and promote corrosion, which depended on the relative content and distribution of the second phases formed.
The results in Table 3 indicate that the increase in the second phase (Ag, Cu)Zn4 promoted the formation of more micro galvanic cells, counteracting any possible protective effect of the corrosion products formed during the immersion test.
3.3. Mechanical Properties
Figure 8 shows the representative stress–strain curves, σ-ε, for alloys A1, A2, A3, and A4 after the thermomechanical processing of homogenization and hot extrusion. This figure shows similar behavior between alloys A2, A3, and A4, which includes high values for elongation percentages, yield stress, and tensile strength. In contrast, the A1 alloy shows fragility and low mechanical properties.
Figure 8.
Representative stress–strain curves for alloys under study.
During deformation, alloys A2, A3, and A4 initially present a first elastic stage, followed by plastic deformation in two stages. The elastic stage manifests itself with a σ-ε line with a high slope until a first local maximum is reached. Here, the first stage of plastic deformation begins, where it is observed that deformation continues and the stress decreases slightly until reaching a local minimum, and subsequently remains approximately constant until the second stage of plastic deformation begins.
In the second stage, the plastic deformation continues, and the stress increases again until the maximum corresponds to the tensile strength and continues decreasing until reaching its maximum deformation before rupture. The shape of the stress–strain curve in the first stage of plastic deformation suggests the presence of the yield point phenomenon. This phenomenon is associated with interactions between solute atoms and dislocations as plastic deformation occurs [36]. The solute atoms tend to concentrate near the dislocations anchoring them.
This is why the material needs to reach maximum stress, the so-called upper yield point, to initiate plastic deformation. Freeing the dislocations from the solutes that anchor them allows them to achieve minimum stress and, subsequently, a low yield point. After this minimum, the deformation continues at approximately constant stress through forming Luders bands [36].
The presence of plastic deformation in two stages has been associated with the mechanisms of mechanical strengthening and plasticity due to hetero deformation [26,27,28], related to the so-called hetero materials that present two or more phases in similar proportions or of the same order of magnitude, as is the case of alloys A2, A3, and A4. Due to the differences between the individual mechanical behavior of the constituent phases and the interface’s characteristics that connect them, they will present a different mechanical behavior than the same phases when found separately. Biphasic hetero materials, made up of a soft metallic phase and a brittle one, show a deformation process under load that consists of three stages [26,37]: at the beginning, the two phases deform elastically until the elastic limit of the soft phase is reached. Its plastic deformation begins while the hard phase continues its elastic deformation. As the plastic deformation occurring in the soft phase is faced with a spatial geometric restriction at the interface with the brittle phase, and given the impossibility of transferring the plastic deformation to the other phase, more dislocations are generated in this area, called geometrically necessary dislocations, GND [26], that contribute to increasing the work hardening of the soft phase.
This process continues until the yield condition of the brittle phase is reached. From that moment on, the brittle phase also begins to deform plastically, generating more dislocations that create more work hardening in both the brittle and ductile phases [26]. Eventually, the formation of microcracks begins in the brittle phase, which contributes to delocalizing the loads and deformations in the two-phase material. These microcracks grow and move towards the interface with the soft phase, where they stop or cross the interface and stop inside the soft phase. This behavior allows the material to plastically deform further, distributing stress and strain into dislocations, twins, and microcracks that do not fatally evolve until the material reaches its limit and fails [26]. Alloys A2, A3, and A4 could fall into the classification of partially laminar hetero materials or with heterogeneous lamella [26,38]; this will be the subject of future research.
The mechanical behavior of alloys A2, A3, and A4 contrasts with the fragility and low mechanical properties of alloy A1, which does not present a second phase. The stress–strain curve of alloy A1 also shows, at the beginning of its plastic deformation, characteristics that suggest the presence of the yield point phenomenon, where the propagation of the Luders bands is manifested in the stress–strain curve by the relatively constant section of serrated stress and with a slightly descending trend, which appears after the high yield point.
It is observed that, unlike alloys A4, A3, and A2, once the propagation of the Luders bands ends in alloy A1, a sudden increase in the stress–strain curve is presented, showing an ascending line and a serrated nature, which suggests the presence of the Portevin–Le Chatelier (PLC) effect [39]. This is another effect of the interactions between dislocations and solute atoms during deformation. When the PLC effect occurs, there is a dynamic migration of solute atoms toward the moving dislocations, which causes their constant blocking, so continuing the sliding of the dislocations, the effort must be increased to unblock them. The mobility of the solutes is such that the blockage occurs again, and it is these successions of the blocking and unblocking processes of dislocations, as the deformation continues, that cause the presence of an ascending, serrated stress–strain curve until the fracture [39].
Table 4 summarizes the values of the mechanical properties determined for the alloys under study. Alloy A4 reached the highest YS value of 375 MPa, UTS = 398 MPa, and % El = 22.6, surpassed in the elongation percentage by alloy A3, which has a % El = 26.6, YS of 360 MPa and UTS = 372 MPa. Alloy A2 shows a slight decrease in mechanical strength and ductility, presenting a YS = 350 MPa and UTS = 366 MPa, as well as an elongation percentage of 18.4%. Alloy A1 shows a YS = 186 MPa and UTS = 237 MPa and an elongation percentage of 7.3%, which is far from meeting the requirements for biomedical alloys. The results shown in Table 3 show that an increase in second phase content increases the yield strength and the UTS of experimental alloys. An increase in second phase content increases the % El, depending on the amount of the second phase and the relative amounts of Ag and Cu.
Table 4.
Tensile test mechanical properties for the alloys under study.
3.4. Evaluation of Antibacterial Properties
Regarding the experimental alloys that satisfied the mechanical properties’ requirements for biomedical applications, at least antibacterial assays were performed in triplicate, and IZD values were averaged. Figure 9 shows the inhibition zones after 24 h of cultivation of the alloys A2, A3, and A4 with S. aureus. A significant bacteriostatic ring around the alloys was confirmed. Table 5 summarizes the inhibition zone diameter (IZD) values of these experimental alloys for S. aureus.
Figure 9.
S. aureus bacterial inhibition halos associated with alloys A2, A3, and A4. (a) A2 alloy, (b) A3 alloy, (c) A4 alloy.
Table 5.
IZD values obtained for the alloys under study.
The antibacterial activity of the alloys under study against S. aureus was measured, and a strong antimicrobial capacity was confirmed in these alloys. The IZD values did not show essential variations between alloys A2, A3, and A4; the highest value of IZD was for alloy A2. However, it is not too far from the values found for alloys A3 and A4, which reached values more than four times what is necessary to consider good antibacterial potential [4]. The results of the antibacterial experiments show that the alloys under study have a good antibacterial effect on S. aureus, which suggests the synergistic antibacterial effect of zinc together with the additions of Cu and Ag and the micro additions of Mg.
These results show that the presence of Ag and Cu in the ranges present in alloys A2, A3, and A4, in addition to helping to increase the mechanical properties within the values required to be used as biomedical alloys, provide these alloys with antibacterial properties that inhibit the growth of the S. aureus bacteria. The alloys show a strong antimicrobial capacity, with IZD values around 5 mm.
3.5. Cytotoxicity
Figure 10 depicts graphically the cell viability shown by the culture medium in contact with different concentrations of the A4 alloy ingot elution after 24 h.
Figure 10.
Percentage of cell viability as a function of elution percentage for alloy A4.
At all elution concentrations, the cell viability percentage is very high, suggesting that the alloy A4 is biocompatible and can be used for biomedical applications. The experimental alloy, with the highest contents of Ag and Cu, shows a very high cell viability percentage at high and low elution concentrations, showing low cytotoxicity.
The results obtained on the effect of the chemical composition on the microstructure and mechanical, corrosion, antibacterial, and cytotoxicity properties of Zn-Ag-Cu-0.05 wt% Mg alloys suggest that it seems possible to adjust the properties of the experimental alloys by changing the contents of Ag and Cu in the composition ranges used in the experiment. Three experimental alloys show properties that indicate excellent potential for use in biomedical applications.
4. Conclusions
- An increment in the Ag and Cu contents increases the amount of the second phase (Ag, Cu)Zn4, improves the mechanical properties, and increases the corrosion rate.
- Experimental alloys showing the second phase exhibit good antibacterial properties against S. aureus and a mechanical behavior similar to that reported for biphasic hetero-materials with heterogeneous lamella.
- The alloy with the highest Ag and Cu contents showed very low cytotoxicity.
- The results suggest that ZnAgCu-0.05 wt% Mg alloys, with Ag and Cu contents in intervals shown by A2, A3, and A4 experimental alloys, show good potential for biomedical applications.
- It seems possible to tune the properties of the ZnAgCu-0.05 wt% Mg alloys by changing the Ag and Cu contents between the experiment’s composition intervals.
5. Patents
Mexican patent application MX/a/2023/009593.
Author Contributions
G.J.-C.: Conceptualization, Investigation, Methodology, Validation, Formal analysis, Writing—original draft. A.A.-V.: Investigation, Methodology, Validation, Supervision, Writing—original draft. B.C.-I.: Resources, Methodology, Validation. M.R.-A.: Resources, Formal Analysis, Writing—review and editing. C.G.-R.: Conceptualization, Investigation, Methodology, Validation, Supervision, Formal Analysis, Funding resources, Project administration, Writing—original draft, Writing—review and editing. All authors have read and agreed to the published version of the manuscript.
Funding
This research was funded by Dirección General de Asuntos del Personal Académico, Universidad Nacional Autónoma de México, grants number IN117019 and IN114321.
Data Availability Statement
The raw data supporting the conclusions of this article will be made available by the authors on request.
Acknowledgments
Gloria Jara-Chávez, as a student registered in the Doctoral Program in Chemical Engineering at the Universidad Nacional Autónoma de México (UNAM) (CVU:630630), thanks CONACYT for the financial support through a Ph.D. scholarship. Jara-Chávez Gloria and González-Rivera Carlos would like to thank Eliezer Hernández Mecinas (IIM UNAM) and Alejandro Camacho Cruz, Ivan Puente Lee, Vianey Torres and Paola Roncagliolo (FQ UNAM) for their support in the mechanical tests, SEM images, antibacterial and corrosion tests of the experimental alloys, respectively.
Conflicts of Interest
The authors declare no conflicts of interest.
References
- Shi, Z.Z.; Gao, X.X.; Zhang, H.J.; Liu, X.F.; Li, H.Y.; Zhou, C.; Yin, Y.X.; Wang, L.N. Design biodegradable Zn alloys: Second phases and their significant influences on alloy properties. Bioact. Mater. 2020, 5, 210–218. [Google Scholar] [CrossRef] [PubMed]
- Qu, X.; Yang, H.; Jia, B.; Wang, M.; Yue, B.; Zheng, Y.; Dai, K. Zinc alloy-based bone internal fixation screw with antibacterial and anti-osteolytic properties. Bioact. Mater. 2021, 6, 4607–4624. [Google Scholar] [CrossRef] [PubMed]
- Yang, N.; Venezuela, J.; Almathami, S.; Dargusch, M. Zinc-nutrient element based alloys for absorbable wound closure devices fabrication: Current status, challenges, and future prospects. Biomaterials 2022, 280, 121301. [Google Scholar] [CrossRef] [PubMed]
- Di, T.; Xu, Y.; Liu, D.; Sun, X. Microstructure, mechanical performance and anti-bacterial activity of degradable Zn-Cu-Ag alloy. Metals 2022, 12, 1444. [Google Scholar] [CrossRef]
- Nie, Y.J.; Dai, J.W.; Zhang, X.B. Effect of Ag Addition on Microstructure, Mechanical and Corrosion Properties of Mg–Nd–Zn–Zr Alloy for Orthopedic Application. Acta Metall. Sin. 2023, 36, 295–309. [Google Scholar] [CrossRef]
- Sikora-Jasinska, M.; Mostaed, E.; Mostaed, A.; Beanland, R.; Mantovani, D.; Vedani, M. Fabrication, mechanical properties and in vitro degradation behavior of newly developed ZnAg alloys for degradable implant applications. Mater. Sci. Eng. C 2017, 77, 1170–1181. [Google Scholar] [CrossRef] [PubMed]
- Tang, Z.; Niu, J.; Huang, H.; Zhang, H.; Pei, J.; Ou, J.; Yuan, G. Potential biodegradable Zn-Cu binary alloys developed for cardiovascular implant applications. J. Mech. Behav. Biomed. Mater. 2017, 72, 182–191. [Google Scholar] [CrossRef]
- Liu, Z.; Qiu, D.; Wang, F.; Taylor, J.A.; Zhang, M. The grain refining mechanism of cast zinc through silver inoculation. Acta Mater. 2014, 79, 315–326. [Google Scholar] [CrossRef]
- Liu, Z.; Qiu, D.; Wang, F.; Taylor, J.A.; Zhang, M. Crystallography of grain refinement in cast zinc–copper alloys. J. Appl. Crystallogr. 2015, 48, 890–900. [Google Scholar] [CrossRef]
- Venezuela, J.; Dargusch, M.S. The influence of alloying and fabrication techniques on the mechanical properties, biodegradability and biocompatibility of zinc: A comprehensive review. Acta Biomater. 2019, 87, 1–40. [Google Scholar] [CrossRef]
- Yue, R.; Huang, H.; Ke, G.; Zhang, H.; Pei, J.; Xue, G.; Yuan, G. Microstructure, mechanical properties and in vitro degradation behavior of novel Zn-Cu-Fe alloys. Mater. Charact. 2017, 134, 114–122. [Google Scholar] [CrossRef]
- Tang, Z.; Huang, H.; Niu, J.; Zhang, L.; Zhang, H.; Pei, J.; Tan, J.; Yuan, G. Design and characterizations of novel biodegradable Zn-Cu-Mg alloys for potential biodegradable implants. Mater. Des. 2017, 117, 84–94. [Google Scholar] [CrossRef]
- Lin, J.; Tong, X.; Wang, K.; Shi, Z.; Li, Y.; Dargusch, M.; Wen, C. Biodegradable Zn–3Cu and Zn–3Cu–0.2 Ti alloys with ultrahigh ductility and antibacterial ability for orthopedic applications. J. Mater. Sci. Technol. 2021, 68, 76–90. [Google Scholar] [CrossRef]
- Wątroba, M.; Bednarczyk, W.; Kawałko, J.; Lech, S.; Wieczerzak, K.; Langdon, T.G.; Bała, P. A novel high-strength Zn-3Ag-0.5 Mg alloy processed by hot extrusion, cold rolling, or high-pressure torsion. Metall. Mater. Trans. A 2020, 51, 3335–3348. [Google Scholar] [CrossRef]
- Wątroba, M.; Bednarczyk, W.; Kawałko, J.; Bała, P. Fine-tuning of mechanical properties in a Zn–Ag–Mg alloy via cold plastic deformation process and post-deformation annealing. Bioact. Mater. 2021, 6, 3424–3436. [Google Scholar] [CrossRef] [PubMed]
- Jin, H.; Li, W.; Chen, L.; Lai, Y.; Guo, H.; Xing, Q.; Yang, X. Effects of Ag Content and Hot-Rolling on Microstructure and Mechanical Properties of Zn-Cu-xAg-Zr Alloy. J. Mater. Eng. Perform. 2022, 31, 5964–5972. [Google Scholar] [CrossRef]
- Jin, H.; Yang, L.; Lai, Y.; Liu, Y. The effects of Zr content and hot rolling on the microstructure and mechanical properties of Zn-1.5 Cu-1.0 Ag-xZr alloys. J. Alloys Compd. 2022, 912, 165116. [Google Scholar] [CrossRef]
- Niu, K.; Zhang, D.; Qi, F.; Lin, J.; Dai, Y. The effects of Cu and Mn on the microstructure, mechanical, corrosion properties and biocompatibility of Zn–4Ag alloy. J. Mater. Res. Technol. 2022, 21, 4969–4981. [Google Scholar] [CrossRef]
- Guillory, I.I.R.J.; Mostaed, E.; Oliver, A.A.; Morath, L.M.; Earley, E.J.; Flom, K.L.; Kolesar, T.M.; Mostaed, A.; Summers, H.D.; Kwesiga, M.P.; et al. Improved biocompatibility of Zn–Ag-based stent materials by microstructure refinement. Acta Biomater. 2022, 145, 416–426. [Google Scholar] [CrossRef]
- Yilmazer, H.; Basit, S.; Sen, A.; Yilmazer, Y.; Dalbayrak, B.; Arisan, E.D.; Arisan, S.; Islamgaliev, R.K.; Dikici, B. A comprehensive study on microstructure, in-vitro biodegradability, bacterial sensitivity, and cellular interactions of novel ternary Zn-Cu-xAg alloys for urological applications. J. Alloys Compd. 2023, 965, 171290. [Google Scholar] [CrossRef]
- Heiss, A.; Thatikonda, V.S.; Richter, A.; Schmitt, L.Y.; Park, D.; Klotz, U.E. Development, Processing and Aging of Novel Zn-Ag-Cu Based Biodegradable Alloys. Materials 2023, 16, 3198. [Google Scholar] [CrossRef] [PubMed]
- Chen, C.; Yue, R.; Zhang, J.; Huang, H.; Niu, J.; Yuan, G. Biodegradable Zn-1.5 Cu-1.5 Ag alloy with anti-aging ability and strain hardening behavior for cardiovascular stents. Mater. Sci. Eng. C 2020, 116, 111172. [Google Scholar] [CrossRef] [PubMed]
- Chen, K.; Ge, W.; Zhao, L.; Kong, L.; Yang, H.; Zhang, X.; Gu, X.; Zhu, C.; Fan, Y. Endowing biodegradable Zinc implants with dual-function of antibacterial ability and osteogenic activity by micro-addition of Mg and Ag (≤0.1 wt.%). Acta Biomater. 2023, 157, 683–700. [Google Scholar] [CrossRef] [PubMed]
- Jin, H.; Zhao, S.; Guillory, R.; Bowen, P.K.; Yin, Z.; Griebel, A.; Schaffer, J.; Earley, E.J.; Goldman, J.; Drelich, J.W. Novel high-strength, low-alloys Zn-Mg (<0.1 wt% Mg) and their arterial biodegradation. Mater. Sci. Eng. C 2018, 4, 67–79. [Google Scholar]
- Ardakani, M.S.; Mostaed, E.; Sikora-Jasinska, M.; Kampe, S.L.; Drelich, J.W. The effects of alloying with Cu and Mn and thermal treatments on the mechanical instability of Zn-0.05 Mg alloy. Mater. Sci. Eng. A 2020, 770, 138529. [Google Scholar] [CrossRef] [PubMed]
- Wu, H.; Fan, G. An overview of tailoring strain delocalization for strength-ductility synergy. Prog. Mater. Sci. 2020, 113, 100675. [Google Scholar] [CrossRef]
- Zhu, Y.; Wu, X. Heterostructured materials. Prog. Mater. Sci. 2023, 131, 101019. [Google Scholar] [CrossRef]
- Zhuo, X.; Wu, Y.; Ju, J.; Liu, H.; Jiang, J.; Hu, Z.; Bai, J.; Xue, F. Recent progress of novel biodegradable zinc alloys: From the perspective of strengthening and toughening. J. Mater. Res. Technol. 2022, 17, 244–269. [Google Scholar] [CrossRef]
- Petzow, G.; Effenberg, G. Ag (Silver) Ternary Alloy Phase Diagrams. In Alloy Phase Diagrams; Okamoto, H., Schlesinger, M.E., Mueller, E.M., Eds.; ASM International: Novelty, OH, USA, 2016; Volume 3, pp. 1501–1502. [Google Scholar]
- Xiao, C.; Wang, L.; Ren, Y.; Sun, S.; Zhang, E.; Yan, C.; Liu, Q.; Sun, X.; Shou, F.; Duan, J.; et al. Indirectly extruded biodegradable Zn-0.05 wt% Mg alloy with improved strength and ductility: In vitro and in vivo studies. J. Mater. Sci. Technol. 2018, 34, 1618–1627. [Google Scholar] [CrossRef]
- ASTME8-04; Test Methods for Tension Testing of Metallic Materials. American Society for Testing and Materials: West Conshohocken, PN, USA, 2004.
- ISO 20645:2004; Textile Fabrics—Determination of the Antibacterial Activity—Agar Diffusion Plate Test. International Organization for Standardization: Geneva, Switzerland, 2004.
- ISO 10993:2009; Biological evaluation of medical devices Part 5: Tests for in vitro cytotoxicity. International Organization for Standardization: Geneva, Switzerland, 2009.
- Xiao, X.; Liu, E.; Shao, J.; Ge, S. Advances on biodegradable zinc-silver-based alloys for biomedical applications. J. Appl. Biomater. Funct. Mater. 2021, 19, 22808000211062407. [Google Scholar] [CrossRef]
- Palai, D.; Roy, T.; Prasad, P.S.; Hazra, C.; Dhara, S.; Sen, R.; Das, S.; Das, K. Influence of copper on the microstructural, mechanical, and biological properties of commercially pure Zn-based alloys for a potential biodegradable implant. ACS Biomater. Sci. Eng. 2022, 8, 1443–1463. [Google Scholar] [CrossRef] [PubMed]
- Qiu, H.; Ueji, R.; Inoue, T. Yield-Point Phenomenon and Plastic Bands in Ferrite–Pearlite Steels. Materials 2022, 16, 195. [Google Scholar] [CrossRef] [PubMed]
- Huang, M.; Fan, G.H.; Geng, L.; Cao, G.J.; Du, Y.; Wu, H.; Zhang, T.T.; Kang, H.J.; Wang, T.M.; Du, G.H.; et al. Revealing extraordinary tensile plasticity in layered Ti-Al metal composite. Sci. Rep. 2016, 6, 38461. [Google Scholar] [CrossRef] [PubMed]
- Zhang, L.; Chen, Z.; Wang, Y.; Ma, G.; Huang, T.; Wu, G.; Jensen, D.J. Fabricating interstitial-free steel with simultaneous high strength and good ductility with homogeneous layer and lamella structure. Scr. Mater. 2017, 141, 111–114. [Google Scholar] [CrossRef]
- Rowlands, B.S.; Rae, C.; Galindo-Nava, E. The Portevin-Le Chatelier effect in nickel-base superalloys: Origins, consequences and comparison to strain ageing in other alloy systems. Prog. Mater. Sci. 2023, 132, 101038. [Google Scholar] [CrossRef]
Disclaimer/Publisher’s Note: The statements, opinions and data contained in all publications are solely those of the individual author(s) and contributor(s) and not of MDPI and/or the editor(s). MDPI and/or the editor(s) disclaim responsibility for any injury to people or property resulting from any ideas, methods, instructions or products referred to in the content. |
© 2024 by the authors. Licensee MDPI, Basel, Switzerland. This article is an open access article distributed under the terms and conditions of the Creative Commons Attribution (CC BY) license (https://creativecommons.org/licenses/by/4.0/).